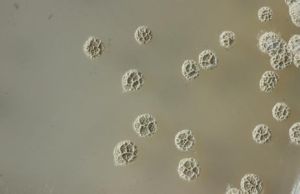
遊動放線菌科

形態特徵
由基內菌絲和(或)氣生菌絲上的孢囊柄,或孢囊菌絲的頂端膨大,或孢子絲盤繞成各種形狀的多孢囊,其直徑由數微米致數十微米,內有許多孢囊孢子,大部分有鞭毛能遊動,少數無鞭毛不能遊動。
基內菌絲纖細,直徑0.2~1.5微米。
多數無氣生菌絲。
生活習性
生長在土壤和水中或各種有機殘體上,一般喜潮濕。產生一些有用的抗生素。
主要屬
基內菌絲纖細,直徑0.2~1.5微米。多數無氣生菌絲。生長在土壤和水中或各種有機殘體上,一般喜潮濕。產生一些有用的抗生素。根據有無氣生菌絲,孢囊形狀、孢囊孢子有無鞭毛以及細胞壁化學組分,將本科分為6屬。
研究
遊動放線菌屬本科中種數較多的1個模式屬。 基內菌絲上常呈柵欄狀的菌絲頂端形成類球形或略不規則孢囊,其中孢囊孢子不規則排列,由孢囊壁破裂或部分溶解而釋放出來;孢囊孢子渾圓形,大部分具極生叢毛,偶有周生鞭毛,能遊動;一般無氣生菌絲;細胞壁化學組分Ⅱ型,即以內消鏇二氨基庚二酸和甘氨酸為特徵組分;DNA中的G+C克分子含量為70.6~76%。
已記述20餘種。基內菌絲多呈橙色,產生多種抗細菌和腫瘤的抗生素。中國發現的濟南遊動放線菌能產生對大腸桿菌有特效的創新黴素。代表種為菲律賓游動放線菌。
小瓶菌屬一般無氣生菌絲,基內菌絲上層柵欄狀菌絲或孢囊柄頂端著生瓶狀、筒形、鈴狀或略不規則的孢囊,其中有大量呈平行直線排列的桿狀孢囊孢子;孢囊孢子大部具極生鞭毛,能遊動;細胞壁化學組分Ⅱ型;DNA中的G+C克分子含量為72.3%。已記述約10個種。代表種為規則小瓶菌。
發仙菌屬一般無氣生菌絲,基內菌絲上形成類球形成筒狀孢囊,含大量成直行排列的桿狀孢囊孢子,孢囊孢子具極生鞭毛,能遊動;細胞壁化學組分Ⅸ型,全細胞水解物含內消鏇二氨基庚二酸以及阿拉伯糖和半乳糖。從水、土中頭髮上分離出兩個種。代表種為陶器發仙菌。
無定形孢囊菌屬一般無氣生菌絲;基內菌絲上形成形狀極不規則的孢囊,常呈裂葉狀,花形,內含卵形至桿狀的孢囊孢子;孢囊孢子有時具極生鞭毛,能緩慢遊動;細胞壁化學組分Ⅱ型;DNA中的G+C克分子含量為71.4%。至今只記述2~3種,代表種為橙色無定形孢囊菌。
螺孢菌屬氣生菌絲除形成分生孢子鏈外,還形成球形至蠕蟲狀孢囊;其中盤繞的孢子絲斷裂為桿狀至螺鏇扭曲的孢囊孢子;孢囊孢子具亞極生叢毛,能遊動;細胞壁化學組分Ⅲ型,全細胞水解物以內消鏇二氨基庚二酸為唯一特徵性組分;DNA中的G+C克分子含量為72.9%。至今只記述了微白螺孢菌1種。
鏈孢囊菌屬氣生菌絲有時形成孢子鏈,經常形成球形孢囊,其中孢子絲規則盤繞,斷裂為卵圓形的孢囊孢子,無鞭毛,不能遊動;細胞壁化學組分Ⅲ型,有時除內消鏇二氨基庚二酸外,還含有跡量左鏇二氨基庚二酸;DNA中的G+C克分子含量為69.5~70.6%。已記述20餘種。產生多種抗細菌和腫瘤的抗生素。代表種為玫瑰鏈孢囊菌。